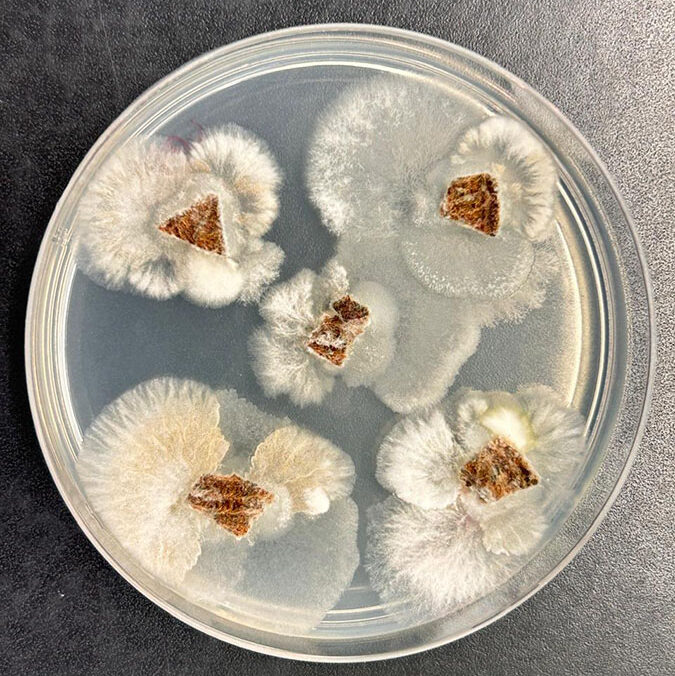

Hace tiempo ya que la agricultura empezó a alejarse paulatinamente de los agroquímicos tradicionales y a echar mano del mundo nuevo que se abrió con los hongos, bacterias y otros microorganismos que demostraron poder convertirse en “aliados invisibles” que traen soluciones muy concretas -y más amigables con el medioambiente- a los problemas que se plantean a diario en el campo.
En esa carrera por el desarrollo de bioinsumos, que avanza a grandes pasos, los laboratorios llevan la delantera, pues es desde ahí donde emergen las primeras ideas y resultados que luego pueden convertirse en productos comerciales concretos. La oferta de este tipo de productos crece cotidianamente, y ya hay muchos biofertilizantes y hasta bioinsecticidas, aunque una gran materia pendiente sigue siendo que no existe por ahora un desarrollo que pueda potencialmente reemplazar a los herbicidas, comenzando por el popular glifosato.
Por eso es que despierta interés una de las últimas novedades que llega desde Brasil, en donde un grupo de investigadores de Embrapa descubrió que un hongo endofítico -es decir, que vive dentro de ciertas plantas- puede aislarse y utilizarse como herbicida y antifúngico, con un efecto aún más potente que los compuestos sintéticos más conocidos, como el glifosato y la clomazona.

Aunque de la investigación básica a la aplicada hay un largo camino, y aún resta llevar a cabo estudios de seguridad, mecanismos de acción y formulación de productos comerciales, lo cierto es que el hallazgo parece, cuanto menos, prometedor.
Según explicaron desde Embrapa, el organismo público brasilero dedicado a la investigación científica, lo que hicieron fue aislar un hongo identificado como Fusarium, que pertenece a la familia Nectriaceae -una de las más presentes del planeta-, y lo sometieron a bioensayos para evaluar su efectividad.
En concreto, los tres metabolitos aislados –anhidrofusarubina, javanicina y el compuesto “2”- mostraron “actividad fitotóxica significativa”, inhibiendo totalmente la germinación de semillas de malezas de la misma manera que un conocido herbicida sintético, el acifluorfeno, en la misma dosis.
Y no sólo eso, sino que además demostraron ser más potentes que el glifosato y la clomazona, ya que arrojaron valores de CI50 muy por debajo que estos, lo que indica que se necesita menos cantidad del compuesto para lograr el mismo efecto.
Este trabajo, en el que participaron científicos de la Universidad Federal de Minas Gerais (UFMG), el Departamento de Agricultura de los Estados Unidos (USDA) y Entorno Embrapa (SP), se basa en realidad en investigaciones previas, que confirmaban la acción antimicrobiana de hongos endófitos de ese tipo. De hecho, el grupo al que pertenece Fusarium es conocido tanto por su capacidad de causar enfermedades en cultivos agrícolas como por producir sustancias de interés biotecnológico.
En este caso, los ensayos se llevaron a cabo sobre semillas de lechuga (Lactuca) y hierba rastrera (Agrostis estolonifera), que son modelos comunes en estudios de herbicidas. Para medir su toxicidad, los estudios adicionales se hicieron con lenteja de agua (Lemna), que es una especie muy usada también en los ensayos de la industria.
El hongo fue aislado de una planta medicinal tropical del género Piper y, de los tres metabolitos que se evaluaron, los resultados más alentadores lo arrojó el “compuesto 2” que, aseguraron desde el organismo brasileño, “mostró un rendimiento comparable o superior a algunos pesticidas sintéticos ya comercializados”.
Con esos resultados alentadores en la mano, el profesor Luiz Henrique Rosa, de la UFMG, aseguró que “el trabajo marca el inicio de un proceso que puede culminar en nuevos herbicidas y fungicidas comerciales”. Por delante, eso demanda una serie de investigaciones adicionales, como la evaluación de rendimiento, el estudio de seguridad ambiental y toxicológica y un estudio pormenorizado de estas moléculas.
A priori, el especialista asegura que “estos microorganismos endófitos son un reservorio prometedor y aún poco explorado de metabolitos bioactivos, capaces de generar soluciones innovadoras para la agricultura”, lo que configura una certeza que no es nueva, pero que ha tomado impulso los últimos años.
Si han aumentado notablemente las investigaciones en torno a los biológicos es porque también se ha incrementado la demanda, en algunos casos como reemplazo a los agroquímicos tradicionales y, en muchos otros, como complemento.
Lo que ha dejado en claro esta industria es que hay mucho potencial aún por explorar en el terreno de estos “aliados invisibles”, frente a una producción de alimentos que cada vez debe ser mayor con recursos cada vez más limitados.
Bien lo expresó el profesor Rosa, que formó parte de este ensayo: “Además de reducir los impactos ambientales y los riesgos para la salud humana, los pesticidas de origen biológico pueden enfrentar uno de los mayores problemas actuales en este campo: la creciente resistencia de plagas y enfermedades a los productos químicos sintéticos convencionales”.






El glifosato es muerte y destruccion de toda flora y fauna , negocio de las multinacionales yankees en complicidad con los agrogarcas sojeros Argentino
Cállate salame .no podés distinguir una planta de eucalipto de una de soja pelotudo
Todo el tiempo existen cambios, nuevos conocimientos, nuevas perspectivas, etc. nuevos contextos.
El glifosato, un quimico , permitio el uso masivo de la siembra directa. Y SD, glifosato y organismos modificados, especialmente soja, permitieron el gran ingreso de dolares durante la decada del 2000 a la Argentina.
Se manejo mal. no se podia decir que un quimico era menos dañino que el agua del mate, porque eso habilitaba a usar cualquier cantidad.
No se hizo la discucion previa para introducir la soja modificada. Y se sabia que el monocultivo es dañino para los suelos, no se previno sobre esto-
Lo que debemos hacer , es preguntarnos porque hacemos todo con poca discusion previa. Falta gente con formacion para hacer estas interpretaciones , o nadie desea escuchar. ??? No lo se.